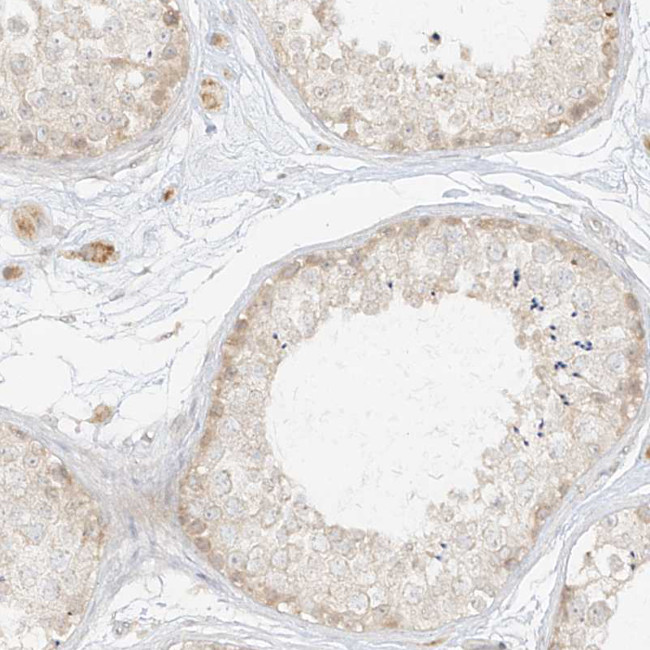
LIPT1 Antibody in Immunohistochemistry (Paraffin) (IHC (P))

Search
Invitrogen
LIPT1 Polyclonal Antibody
{{$productOrderCtrl.translations['antibody.pdp.commerceCard.promotion.promotions']}}
{{$productOrderCtrl.translations['antibody.pdp.commerceCard.promotion.viewpromo']}}
{{$productOrderCtrl.translations['antibody.pdp.commerceCard.promotion.promocode']}}: {{promo.promoCode}} {{promo.promoTitle}} {{promo.promoDescription}}. {{$productOrderCtrl.translations['antibody.pdp.commerceCard.promotion.learnmore']}}
产品信息
PA5-57064
种属反应
宿主/亚型
分类
类型
抗原
偶联物
形式
浓度
规格
纯化类型
保存液
内含物
保存条件
运输条件
RRID
产品详细信息
Immunogen sequence: TDGTFLSSLL KSPYQGIRSN ATASIPSLVK NLLEKDPTLT CEVLMNAVAT EYAAYHQIDN HIHLINPTDE TLFPGINSKA KELQTWEWIY GKTPK
Highest antigen sequence identity to the following orthologs: Mouse - 75%, Rat - 77%.
靶标信息
The process of transferring lipoic acid to proteins is a two-step process. The first step is the activation of lipoic acid by lipoate-activating enzyme to form lipoyl-AMP. For the second step, LIPT1 transfers the lipoyl moiety to apoproteins.The process of transferring lipoic acid to proteins is a two-step process. The first step is the activation of lipoic acid by lipoate-activating enzyme to form lipoyl-AMP. For the second step, the protein encoded by this gene transfers the lipoyl moiety to apoproteins. Alternative splicing in the 5' UTR of this gene results in five transcript variants that encode the same protein.
仅用于科研。不用于诊断过程。未经明确授权不得转售。
生物信息学
蛋白别名: Lipoate biosynthesis protein; Lipoate-protein ligase; Lipoyl amidotransferase LIPT1, mitochondrial; Lipoyl ligase; Lipoyltransferase 1; lipoyltransferase 1, mitochondrial
基因别名: LIPT1; LIPT1D
UniProt ID: (Human) Q9Y234
Entrez Gene ID: (Human) 51601